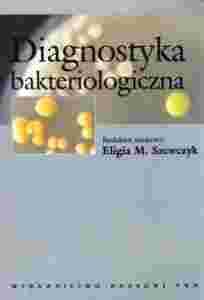

DIAGNOSTYKA BAKTERIOLOGICZNA - ELIGIA M. SZEWCZYK
Aukcja w czasie sprawdzania była zakończona.
Cena kup teraz: 30.50 zł
Użytkownik makaroniarz_2006
numer aukcji: 5449972470
Miejscowość Warszawa
Wyświetleń: 5
Koniec: 24-06-2015, 7:41
Dodatkowe informacje:
Stan: Nowy
Okładka: miękka
Rok wydania (xxxx): 2011
Kondycja: bez śladów używania
